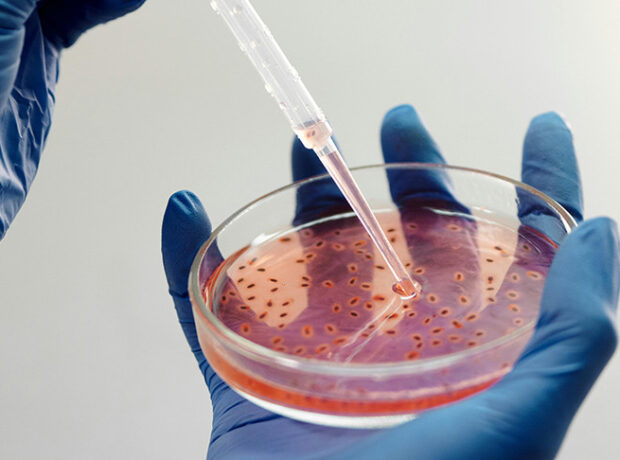
image-1

Rusiya universitetinin mətbuat xidmətinin TASS agentliyinə verdiyi məlumata görə, Novosibirsk Dövlət Universitetinin alimlər qrupu, əvvəllər hazırlanmış, immun stimullaşdırıcı gen və əlavə mutasiyaya malik onkolitik virusun sağlam hüceyrələrə minimal zərər verərkən xərçəng hüceyrələrini məhv etməyə qadir olduğunu aşkar edib.
Onkolitik virusun xərçəng hüceyrələrini səthinin xüsusiyyətləri sayəsində xüsusilə tanıdığı və nüfuz etdiyi müəyyən edilmişdir. Bədxassəli bir hüceyrənin içərisinə daxil olduqdan sonra virus replikasiya üçün daxili mexanizmlərindən istifadə edir və nəticədə hüceyrə membranının yırtılmasına və hüceyrə ölümünə səbəb olur.
Tədqiqatın müəlliflərindən biri və NSU-nun magistr tələbəsi Anastasiya Pakın sözlərinə görə, təcrübələr nəticəsində yalnız şiş hüceyrələrini yoluxduran və sağlam hüceyrələrə minimal zərər verən onkolitik virus yaradılıb. Lakin tədqiqatçı əlavə edib ki, belə bir virus təbiətdə tapılmır və yalnız laboratoriya şəraitində istehsal edilə bilər.
Qeyd olunur ki, onkolitik virus iltihab əleyhinə sitokinlər kimi digər molekulları da aktivləşdirir, buna görə də şiş əleyhinə reaksiya yalnız ilkin şiş yerini deyil, həm də bədəndəki metastazları məhv edə bilər.